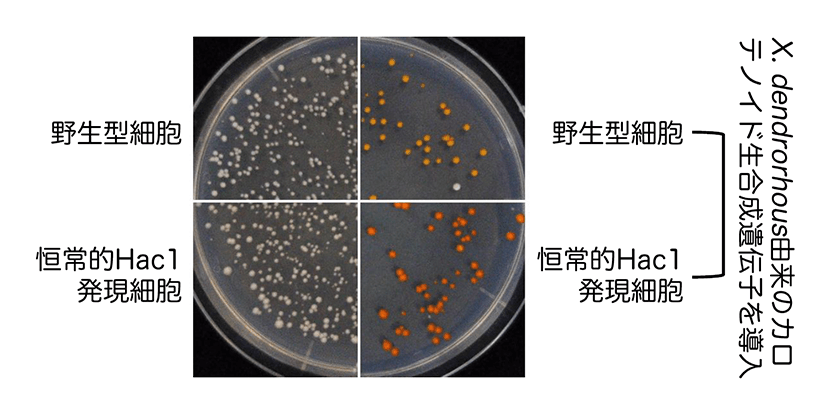

2026.04.01
酵母による有用分泌タンパク質や脂質の生産~小胞体ストレス応答の応用~
オルガネラ制御生物学研究室・助教・木俣(石渡)有紀
- 要旨
-
他種生物由来の分泌タンパク質や脂質類の酵母を用いた代替生産は、注目度が高いバイオテクノロジーです。小胞体はこれらの有用物資の生産工場となるオルガネラであり、小胞体の機能を人為的に高めることができれば、産物の量や質の向上に繋がると期待されます。酵母に遺伝子操作を施すことにより、本来は小胞体がダメージを受けた際に発動する小胞体ストレス応答を、常に引き起こすことが可能となり、そのような酵母では、小胞体の機能やサイズが増大します。しかし、そのような酵母は増殖が遅く、実用に供することが困難です。私たちの研究では、ヒストン脱修飾酵素遺伝子を欠損することによってその欠点を克服し、 高い有用物質生産能を示す酵母株を作り出すことに成功しています。
- 主要関連論文
- Ishiwata-Kimata Y, Nguyen PTM, Sugimoto M, and Kimata Y. (2025) Potential of a constitutive-UPR and histone deacetylase A-deficient Saccharomyces cerevisiae strain for biomolecule production." Appl. Environ. Microbiol. 91, e0064425.
1. 酵母とその応用
酵母とは単細胞で増殖する真菌類の総称あり、2千近くの種が知られています。代表的な酵母種であるサッカロマイセス・セレビシエは、細胞の端から芽を出して増えることから、出芽酵母とも呼ばれています。出芽酵母は、糖分を分解してエタノールや二酸化炭素を作る能力が強く、酒造や製パンの分野で馴染みの深い生物です。一方、真菌類は動植物と同じく真核生物なので、細胞内のさまざまな仕組みが共通しており、安価かつ迅速に増殖できる酵母にいくつかの遺伝子操作を施し、動植物が作っている物質を作らせようとする試みも進んでいます。例えば、医薬品として用いるヒト由来の分泌タンパク質や、動植物由来の脂質類です。
2.小胞体と小胞体ストレス応答
動植物や酵母など、あらゆる真核生物が有する小胞体は、オルガネラのひとつであり、扁平、あるいは棒状の袋として存在しています。細胞外に分泌されるタンパク質、そして脂質類の多くは、小胞体にて合成されます。ですから、小胞体のサイズや能力を高めることができれば、これらの有用物質の収量を高めることが可能となるでしょう。そして、私たちが研究対象としている小胞体ストレス応答(Unfolded Protein response: UPR)は、そのために役立てることができます。
真核生物細胞が有害な刺激を受け、小胞体がダメージを受ける状態を、小胞体ストレスと呼びます。例えば、ウィルスは小胞体を利用して増殖することが多く、ウィルスに感染した細胞は小胞体ストレス状態になります。小胞体ストレスが起きると、分泌タンパク質の形成(折り畳み)が上手く進まなくなり、構造が異常なタンパク質が小胞体の内部に蓄積します。小胞体ストレス状態の細胞は、小胞体で働くタンパク質の量を増やし、小胞体の機能を活発化させ、小胞体ストレスを解消しようとします。これが小胞体ストレス応答です。
出芽酵母の小胞体ストレス応答の仕組みについては研究が進んでおり1)、その概要を図1に示します。小胞体膜に存在するIre1は小胞体ストレスを感知するセンサーとなるタンパク質であり、小胞体の内部に蓄積した異常なタンパク質を認識して自己会合します。その状態のIre1から発せられるシグナルにより、Hac1タンパク質の細胞内の存在量が上昇します。Hac1は転写因子であり、小胞体で働くタンパク質をコードする多数の遺伝子の発現を促し、その結果、小胞体の機能が活発化して、小胞体ストレスは解消されます。

図1.出芽酵母の小胞体ストレス応答
小胞体膜貫通タンパク質Ire1は、小胞体ストレスセンサーとして機能し、小胞体ストレスによって生じた折り畳み不全タンパク質を認識して自己会合します。その状態のIre1から発せられるシグナルに応じて、転写因子タンパク質Hac1の存在量が増大し、様々な遺伝子の発現が促されます。
3. 非ストレス状態でも小胞体ストレス応答を引き起こす酵母株の作出と応用
この現象を利用して、酵母細胞にて小胞体ストレス応答を人工的に引き起こし、非ストレス状態でも小胞体の機能を高める試みは、20年ほど前から行われてきました2)。すなわち、Hac1をコードする遺伝子に操作を施し、ストレスが無い状態でも、Hac1が常に作られるようにするのです。このような恒常的Hac1発現細胞は、分泌タンパク質の小胞体における折り畳みや成熟に関わるタンパク質の発現量が増え、異種性分泌タンパク質の生産性が向上することがあります。また、図2で示すように、恒常的Hac1発現出芽酵母では小胞体が伸展し、扁平な形状の小胞体が細胞の中で目立つようになります3)。しかし、恒常的Hac1発現出芽酵母は増殖が極めて遅く、実用的・産業的なタンパク質分泌生産に供する際の大きなデメリットとなります2)3)。
私たちが最近発表した論文では、そのデメリットを解消すべく行った研究が報告されています4)。この研究において私たちは、ヒストンの化学修飾に関わる酵素をコードする遺伝子の欠失により、恒常的Hac1発現出芽酵母は、強い小胞体ストレス応答を起こしつつも、増殖が速くなることを見出しました。ヒストンとは、核内でDNAを巻き取り、コンパクトなクロマチン構造を形成するタンパク質複合体です。なぜ、ヒストンの化学修飾の変化によって恒常的Hac1発現出芽酵母の増殖が加速するのか、その答えはまだ得られていません。
そしてこの論文では、増殖遅延が回復した恒常的Hac1発現出芽酵母における物質生産能を調べました。前述のように、小胞体は分泌タンパク質だけでなく、さまざま脂質類の合成の場所でもあります。その酵母株は、異種性の分泌タンパク質に加え、油脂を豊富に生成し、多くの脂肪滴を形成することも分かりました。また、図3で示すように、異種性の脂質系分子の合成量も、その酵母株では上昇していました。
図3 小胞体ストレス応答の恒常的活性化による異種性脂質系分子(βカロテン)の増産
出芽酵母に他種生物由来のカロテノイド生合成遺伝子を導入した場合、βカロテンが作られ、寒天培地上で細胞を増殖させると、色づいているのが観察されます。恒常的Hac1発現株は、野生型株よりも多くのβカロテンを合成し、濃い色を呈します。
4. おわりに
医薬品として使われるヒト由来分泌タンパク質としては、現在でも、分子量が小さなインスリンなどは酵母を用いて生産されています。しかし、抗体など分子量が大きなタンパク質は、培養に手間やコストがかかる哺乳動物培養細胞から作る必要があり、薬価の高騰を招いています。酵母を用いて分泌タンパク質をさらに効率よく産生する技術が開発できれば、現在では極めて高価な抗体医薬品も、世界中の人が使えるようになるでしょう。また、酵母を用いて希少な脂質類を代替生産できれば、それを産生する動植物の乱獲防止など、生態系の保全にも繋がると期待されます。
小胞体は分泌タンパク質や脂質類の工場となる細胞内小器官です。通常の状態でも小胞体ストレス応答を引き起こし、小胞体の機能やサイズを高めるという私たちの試みは、これら有用物質の生産に資すると考えています。しかし、それだけでは十分ではありません。この技術を「細胞の代謝系の流れを変える」「小胞体から細胞表面にタンパク質を運ぶ輸送経路を強化する」など、他の遺伝子改変と組み合わせることにより、さらに高性能な酵母株を作り出せると考えており、これからも研究を続けます。
参考文献
木俣(石渡)有紀 NAIST Edge BIO, 0035. (2026)


